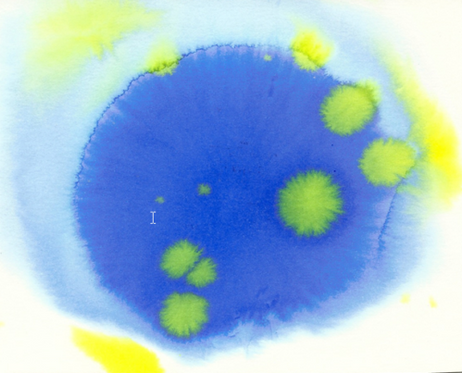

galería Ra del Rey. Espacio para las Artes



Carmen Pallarés
Se dio a conocer gracias a obras como Del lado de la ausencia (Aeda, 1979), Molino de agua (Rialp, 1980), La llave de grafito (Rialp, 1983), Caravanserai (Esquío, 1987), Antología 1979-1986 (Puerta del mar, 1987), Luces de travesía (Libertarias, 1989) y Abba (Libertarias/Prodhufi, 1995). Más recientemente ha editado algunos poemarios que tampoco han pasado desapercibidos, como es el caso, entre otros, de Esgrima (Trea, 2005). Además, fue importante para su proyección pública su aparición en las antologías Las diosas blancas y Ellas tienen la palabra, que Hiperión publicó en 1985 y 1998, respectivamente. Es una pintora de trayectoria dilatada y profesionalmente ha ejercido como periodista especializada en información cultural y crítica de arte.
Pascual Tarazona
Nacido en Paiporta, Valencia, España, ha vivido en Madrid, París, Londres y Johannesburgo. En Madrid estudió teatro, cine y moda. En París y Londres, trabajó en la industria de la moda, asistiendo también al St Martín’s School of Art. En 1975 se trasladó a Johannesburgo, Sudáfrica, donde destacó como diseñador de moda, siendo premiado con el Coty Desirgner en el año 1981 y con el Coty Avant Garde en el año 1983. Durante la década de 1990 el artista entró en el dominio de las artes visuales y desde entonces ha trabajado en ello a tiempo completo, realizando exposiciones individuales en Pretoria, Johannesburgo y Madrid, y participándo en numerosas exposiciones colectivas.
Carmen Pallarés
Pascual Tarazona